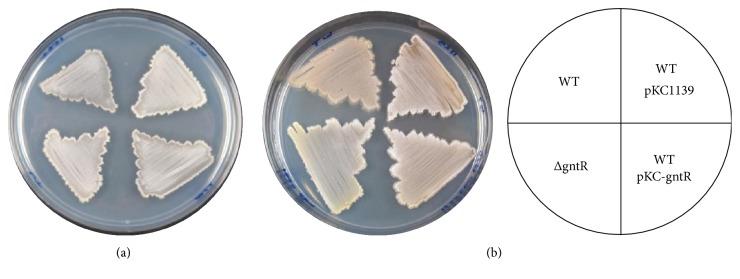
https://cdn.ncbi.nlm.nih.gov/pmc/blobs/b7b7/5425828/201b8d4fcd92/BMRI2017-9529501.002.jpg

GntR家族调控基因在M145菌株葡萄糖酸代谢中的作用
Role of GntR Family Regulatory Gene in Gluconate Metabolism in M145.
作者信息
Tsypik Olga, Makitrynskyy Roman, Bera Agnieszka, Song Lijiang, Wohlleben Wolfgang, Fedorenko Victor, Ostash Bohdan
机构信息
Department of Genetics and Biotechnology, Ivan Franko National University of Lviv, Lviv 79005, Ukraine.
Microbiology and Biotechnology, Interfaculty Institute of Microbiology and Infection Medicine, University of Tübingen, Tübingen, Germany.
出版信息
Biomed Res Int. 2017;2017:9529501. doi: 10.1155/2017/9529501. Epub 2017 Apr 27.
Here we report functional characterization of the M145 gene which encodes a GntR-like regulator of the FadR subfamily. Bioinformatic analysis suggested that is part of putative operon involved in gluconate metabolism. Combining the results of knockout, transcriptional analysis of operon, and Sco1678 protein-DNA electromobility shift assays, we established that Sco1678 protein controls the gluconate operon. It does so via repression of its transcription from a single promoter located between genes and . The knockout also influenced, in a medium-dependent manner, the production of secondary metabolites by . In comparison to the wild type, on gluconate-containing minimal medium, the mutant produced much less actinorhodin and accumulated a yellow-colored pigment, likely to be the cryptic polyketide coelimycin. Possible links between gluconate metabolism and antibiotic production are discussed.
在此,我们报道了M145基因的功能特性,该基因编码FadR亚家族的一种类GntR调节因子。生物信息学分析表明,它是参与葡萄糖酸盐代谢的假定操纵子的一部分。结合基因敲除、操纵子转录分析以及Sco1678蛋白-DNA电泳迁移率变动分析的结果,我们确定Sco1678蛋白控制葡萄糖酸盐操纵子。它通过抑制位于基因和之间的单个启动子的转录来实现这一点。基因敲除还以培养基依赖的方式影响了该菌次级代谢产物的产生。与野生型相比,在含葡萄糖酸盐的基本培养基上,该突变体产生的放线紫红素少得多,并积累了一种黄色色素,可能是隐性聚酮化合物天蓝色菌素。本文讨论了葡萄糖酸盐代谢与抗生素生产之间的可能联系。